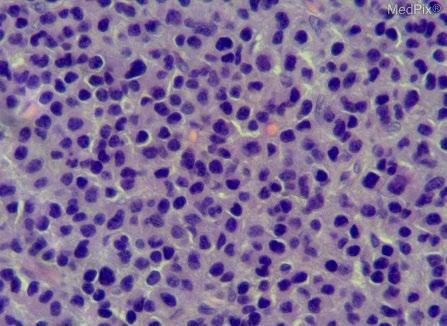

Welcome!
Thank you for joining us today for the April 22, 2023, International Myeloma Foundation’s Regional Community Workshop –Seattle.


Thank you for joining us today for the April 22, 2023, International Myeloma Foundation’s Regional Community Workshop –Seattle.











April 22, 2023, Agenda

9:00 – 9:15 AM Welcome and Announcements
Kelly Cox, Director of Support Groups, Senior Director Regional Community Workshops

9:15 – 9:45 AM Myeloma 101

Rafat Abonour, MD - University of Indiana
9:45 – 9:55 AM Q&A
9:55 – 10:40 AM Life is a Canvas, You are the Artist
Mary Steinbach, DNP, APRN – Huntsman Cancer Institute/University of Utah; IMF Nurse Leadership Board
10:40 – 10:50 AM Q&A
10:50 – 11:00 AM COFFEE BREAK 11:00 – 11:45 AM Frontline Therapy
Andrew Cowan, MD – University of Washington 11:45 – 11:55 AM Q&A
11:55 AM – 12:40 PM LUNCH BREAK
April 22, 2023, Agenda
12:40 – 1:00 PM Local Patient & Care Partner Panel
Annie Taussig , Patient Advocate and John Taussig, Care Partner
1:00 – 1:10 PM Q&A
1:10 – 1:30 PM Maintenance Therapy
Andrew Cowan, MD – University of Washington
1:30 – 1:40 PM Q&A
1:40 – 2:25 PM Relapsed Therapies & Clinical Trials

Rafat Abonour, MD – University of Indiana
2:25 – 2:35 PM Q&A
2:35 – 2:45 PM Closing Remarks

2:45 – 3:00 PM Coffee / Network






. The IMF provides FREE resources to help both patients and families.
Established in 1990, the IMF’s InfoLine assists over 4600 callers annually and answers questions across a wide variety of topics including:
Frequent topics:

Newly Diagnosed MM/Myeloma 101
Treatment Options
Transplant
Maintenance
Side Effects
Relapsed/Refractory MM
Clinical Trials

Resources for Drug Access/Financial Support/Local Support
Referrals to Myeloma Specialists Within/Outside the US
Health Issues Related to Myeloma


Caregiver Support
Paul Hewitt, Missy Klepetar, and Deb Verla






















A core mission of the IMF is to provide thorough and cutting-edge education to the myeloma community.














Harry and Edith Gladstein Professor of Cancer Research
Professor of Medicine, Pathology and Laboratory Medicine
Director, Multiple Myeloma, Waldenstrom's Disease and Amyloidosis Program
Indiana University School of Medicine


MM is the second most common hematologic malignancy in adults1
The disease is characterized by the buildup of malignant plasma cells, or myeloma cells, in the bone marrow 1

Myeloma cells produce an excess of monoclonal immunoglobulins, also known as monoclonal proteins (M-proteins)1,2

• Excess M-proteins in the blood can cause hyperviscosity, platelet dysfunction, and renal tubular damage3
.
https://www.ncbi.nlm.nih.gov/books/NBK534764/. Accessed November
Top image is open access from National Cancer Institute Visuals Online; bottom image is open access from MedPix® (synpic37150.jpg). MM=multiple myeloma. 1. Caraccio C, et al. Front Immunol. 2020;11:501. 2. Cho S-F, et al. Front Immunol. 2018;9:1821. 3. Albagoush SA, et al. Multiple myeloma. StatPearls. Stat Pearls Publishing; 2021

Myeloma is a disease where the immune system falls apart
Plasma cells become malignant
T cells become ineffective


B cell
SURVEILLANCE
“RIGHT FIT”
Plasma cell
REPLICATION & MASSIVE ANTIBODY PRODUCTION


• Myeloma = too many plasma cells
• Each myeloma cell (clone) makes and releases one type of antibody (gamma globulin) into the circulation (monoclonal gammopathy)

Light Chain
Heavy Chain
Kappa releasing Lambda releasing Kappa, κ Lambda, λSerum Protein electrophoresis (sPEP)


Normal profile
Monoclonal protein = M-spike
MAYO CLIN PROC. 2001;76:476-487
© 2001 MAYO FOUNDATION FOR MEDICAL EDUCATION AND RESEARCH











• > 3 focal lesions or SUV > 4.2 at diagnosis results in shorter PFS and OS[1]
• 65% of pts PET/CT negative 3 mos after ASCT with longer PFS and OS vs PET positive[1]

• Complete FDG suppression associated with durable disease control and prolonged OS[1]

• Skeletal survey recommended in cases of plasmacytoma, extramedullary disease, suspected spinal cord compression as well as with new symptoms or progression[2]
• MRI and/or PET/CT indicated when symptomatic areas show no abnormality on radiograph[3]
 1. Zamagni E, et al. Blood. 2011;118:5989-5995.
2. Ludwig H, et al. Leukemia. 2014;28:981-992.
3. NCCN. Clinical practice guidelines in oncology: multiple myeloma. v.2.2014. 4. Boot M, et al. Novel prognostic modalities in multiple myeloma. 2013.
MRI FDG PET
Imaging Techniques[4]
1. Zamagni E, et al. Blood. 2011;118:5989-5995.
2. Ludwig H, et al. Leukemia. 2014;28:981-992.
3. NCCN. Clinical practice guidelines in oncology: multiple myeloma. v.2.2014. 4. Boot M, et al. Novel prognostic modalities in multiple myeloma. 2013.
MRI FDG PET
Imaging Techniques[4]

DNA
Conventional cytogenetic analysis (karyotyping)


FISH (fluorescence in situ hybridization)

Advances
• Genetic expression profiling [GEP]

• Whole-genome/ whole-exome sequencing)
 Myeloma
Myeloma




Rate of new cases per 100,000 persons by race/ethnicity and sex1
Male
Hispanic
American Indian/Alaska Native
Asian/Pacific Islander
Black
Men are slightly more likely than women to develop MM2
The rate of MM is 2 times higher in Black patients than in White patients1,2
– Multifactorial reasons possibly include family history and genetic factors3

White
All Races
National statistics are reported according to 4 race categories (White, Black, Asian/Pacific Islander, American Indian/Alaska Native) and Hispanic ethnicity. Ethnicity is not mutually exclusive from the race categories.
MM=multiple myeloma.
1. National Cancer Institute. https://seer.cancer.gov/statfacts/html/mulmy.html. Accessed November 29, 2022. 2. American Cancer Society. https://www.cancer.org/cancer/multiple-myeloma/causes-risks-prevention/risk-factors.html. Accessed November 29, 2022. 3. Marinac CR, et al. Blood Cancer J. 2020:10:19.
Potential factors of MM disparities in Black patients1-6
Awareness of MM is low despite increased prevalence
Trust in the healthcare system may be low , which may contribute to hesitancy in seeking medical care, treatment initiation, and delay in diagnosis
Access to healthcare and use of established and novel therapies are more limited
Family history and genetic susceptibility increase risk of MM
Clinician bias may be present
Potential strategies to reduce disparities in care of patients with MM include improving access to health care resources, increasing awareness of MM among patients, and education for providers and patients1,3-6
MM=multiple myeloma.
1. National Cancer Institute. https://www.cancer.gov/about-nci/organization/crchd/blog/2017/multiple-myeloma-disparities. Accessed November 29, 2022. 2. Lillie-Blanton M, et al. Med Care Res Rev. 2000;57 (suppl 1):218-235. 3. Pierre A, et al. Clin J Oncol Nurs. 2020;24(4):439-443. 4. International Myeloma Foundation (IMF). https://www.myeloma.org/diversity/are-some-disparities-treatment-caremultiple-myeloma-patients. Accessed November 29, 2022. 5. Habr D, Corsaro M. Hematol Oncol. 2022;40(4):689-694. 6. Marinac CR, et al. Blood Cancer J. 2020;10(2):19.

Healthcare disparities impact the care and treatment of patients with MM, especially Black patients
• At least one of the CRAB Criteria (evidence of end organ damage)
Hypercalcemia
Serum calcium >2.75 mmol/L (>11 mg/dL)
Renal Failure
Serum creatinine ≥ 2 mg/dL or creatinine clearance <40 mL per min

Anemia
Hemoglobin >20 g/L below the lower limit of normal, or a hemoglobin value <100 g/L
Bone
Lytic lesions, pathologic fractures, or severe
osteopenia
• ≥60% clonal bone marrow plasma cells
• Serum involved/uninvolved free light chain ratio ≥100
• >1 Focal bone lesion (≥5mm) on MRI
• Use your Clinical judgment when using these criteria
Rajkumar, et al. Lancet Oncology. 2014;15(12):e538-48.
Percentage of newly diagnosed patients with the abnormality Risk Group
MM is a collection of several cytogenetically distinct plasma cell malignancies

Cytogenetic abnormalities can influence disease course, response to therapy, and prognosis
MM=multiple myeloma; mSMART=Mayo Stratification of Myeloma and Risk-Adapted Therapy. Rajkumar SV. Am J Hematol. 2020;95:548-567
Double-hit: any 2 high-risk factors
Triple-hit: any 3 or more high-risk factors
Cytogenetic classification is an important factor to consider when evaluating MM prognostic riskMayo clinic risk stratification for MM (mSMART)
Stage I1
All of the following:
• Serum albumin ≥3.5 g/dL
• Serum beta-2-microglobulin <3.5 mg/L
• No high-risk cytogenetics
• Normal serum lactate dehydrogenase level
R-ISS combines elements of tumor burden and disease biology, including high-risk cytogenetic abnormalities1
Stage II1
• Not fitting Stage I or III
Used as a prognostic index in clinical care1

Stage III1,2
• Serum beta-2-microglobulin ≥5.5 mg/L And
• Either high risk cytogenetics [t(4;14), t(14;16), or del(17p)] OR elevated serum lactate dehydrogenase level
MM=multiple myeloma; R-ISS=Revised International Staging System.
1. Rajkumar SV. Am J Hematol. 2020;95(5):548-567. 2. International Myeloma Foundation. https://www.myeloma.org/international-staging-system -iss-reivised-iss-r-iss. Accessed November 29, 2022.

MM is considered an incurable disease with inevitable relapse in most patients1,2
Disease
MGUS=monoclonal gammopathy of undetermined significance; MM=multiple myeloma. 1.

Disease activity

Active disease Remission
(paraprotein level)
TTP 13 months; 58% CR/VGPR
The proportion of patients receiving treatment decreases with each line of therapy1,2
Median TTP 18 months; 74% CR/VGPR
Proportion of patients receiving treatment at each line of therapy (%)
2014 data from retrospective analysis of 4997 patient charts in Belgium, France, Germany, Italy, Spain, Switzerland, and the United Kingdom.1,2 CR=complete response; MM=multiple myeloma; TTP=time to progression; VGPR=very good partial response.
1. Bird SA, et al. Palliat Care Soc Pract. 2019;13:1178224219868235. 2. Yong K, et al. Br J Haematol. 2016;175(2):252-264.
TTP 7 months; 43% CR/VGPR
Over time, MM patients tend to have shorter remissions and lesser responses to standard treatments1,2
• Symptom Control
• Ameliorate pain and other disease-related symptoms
• Prevent further organ damage
• Preserve and improve performance status and quality of life
• Disease Response and Survival
• Rapid cytoreduction to relieve symptoms
• Minimize treatment-related toxicity
• Prolong survival – Overall Survival

A patient is diagnosed with MM when the following criteria are met:

PLASMA CELLS
CRAB
MDEs
• Clonal bone marrow plasma cells (myeloma cells) ≥10%1 OR
• Biopsy-proven bony (ie, in the bone marrow) or extramedullary (ie, outside the bone marrow) plasmacytoma,2 which is a single plasma cell tumor3
• Any one or more of the following2:
– Calcium level increase
– Renal dysfunction
– Anemia
– Bone lesions
• Any one or more of the following biomarkers of MM (called SLiM)1,2:
– ≥60% (Sixty) clonal plasma cells (myeloma cells) on bone marrow examination
– Serum involved/uninvolved Free Light Chain ratio of ≥100*
*Provided the absolute level of the involved light chain is at 100 mg/L (a patient’s involved free light chain is the one that is above the normal reference range; the uninvolved free light chain is the one that is typically in, or below, the normal range).2
CRAB=calcium level increase, renal dysfunction, anemia, bone lesions; IMWG=International Myeloma Working Group; MDE=myeloma-defining events; MM=multiple myeloma; MRI=magnetic resonance imaging.
1. Visram A, et al. Hematology Am Soc Hematol Educ Program 2021;2021(1):673-681. 2. International Myeloma Foundation (IMF). https://www.myeloma.org/international-myeloma-working-group-imwgcriteria-diagnosis-multiple-myeloma. Accessed December 10, 2022. 3. National Cancer Institute. https://www.cancer.gov/publications/dictionaries/cancer-terms/def/plasmacytoma. Accessed December 10, 2022.
CALCIUM LEVEL INCREASE
• Bone breakdown due to myeloma cell growth causes high calcium levels in blood3
• Hypercalcemia refers to serum calcium >0.25 mmol/L (>1 mg/dL) higher than the upper limit of normal or >2.75 mmol/L (>11 mg/dL)4
RENAL DYSFUNCTION
• Excretion of M-proteins through the kidneys can cause damage3
• Renal insufficiency refers to creatinine clearance <40 mL/min or serum creatinine >177 μmol/L (>2 mg/dL)4
ANEMIA




• Myeloma cells infiltrate bone marrow and inhibit normal blood cells production3


• Anemia refers to hemoglobin value of >20 g/L below the lower limit of normal or a hemoglobin value <100 g/L4

BONE LESIONS
• Bone pain and weakness often leads to bone fractures3
• Bone lytic lesions refers to one or more osteolytic lesions on skeletal radiography, MRI, CT, PET, PET-CT, or low-dose WB-CT4
• If bone marrow has <10% clonal plasma cells, more than one bone lesion is required to distinguish from solitary plasmacytoma with minimal marrow involvement4

CT=computerized tomography; MM=multiple myeloma; MRI=magnetic resonance imaging; PET=positron emission tomography; WB-CT=whole body computerized tomography. 1. Bao L. Cancer Med. 2020;9(23):8962-8969. 2. International Myeloma Foundation (IMF). https://www.myeloma.org/international-myeloma-working-group-imw g-criteria-diagnosis-multiple-myeloma. Accessed December 10, 2022. 3. American Cancer Society (ACS). https://www.cancer.org/cancer/multiple-myeloma/about.html. Accessed December 7, 2022. 4. Rajkumar SV. Am J Hematol. 2020;95(5):548-567.

The clinical features of symptomatic MM include calcium level increase, renal dysfunction, anemia, and bone lesions (CRAB)1
The CRAB criteria describe evidence of end-organ damage that can be attributed to the underlying plasma cell proliferative disorder2
Disease Therapy Patient
• Disease burden/stage1
– Bone marrow burden
– CRAB symptoms

– Proliferation markers
• Cytogenetic risk2
– Standard vs high risk
• Type and response to prior therapy2
• Sequencing of treatment options2
• Regimen-related toxicity3
• Reimbursement/access2
• Age2
• Performance status/frailty2
• Comorbidities2
• Bone marrow reserve2
• Patient preferences2
• Eligibility for clinical trial2
• Quality of life3
• Care partner/social support4
CRAB=calcium level increase, renal dysfunction, anemia, bone lesions; MM=multiple myeloma.
Accessed December 10, 2022. 4. Tariman JD, et al. Cancer Treat Commun. 2014;2(2-3):34-47.
1. Gleason C, Kaufman J. J Adv Pract Oncol. 2017;8(3):285-290. 2. van de Donk, NWCJ. Hematology Am Soc Hematol Educ Program. 2020;2020(1):248-258. 3. Dhakal B. Treating Relapsed and/or Refractory Multiple Myeloma in the Complex Treatment Landscape. In: The Hematologist ASH News and Reports. Washington, DC: American Society of Hematology, 2020;17(6). https://ashpublications.org/thehematologist/article/464323/Treating-Relapsed-and-or-Refractory-Multiple.Goals of therapy in MM center around achievement of deep and durable responses while maintaining patient quality of life1,2

Induce remission (a reduction in plasma cells/M-protein to a very low/undetectable level)1,2
Prolong OS1
Aim for a rapid, deep, and durable response1,3
Improve patient’s daily functioning and preserve QoL1


Achieve prolonged PFS3
Minimize adverse events1

MM=multiple myeloma; OS=overall survival; PFS=progression-free survival; QoL=quality of life.
1. Multiple Myeloma Research Foundation. https://themmrf.org/wp-content/uploads/2020/05/MMRF-Treatment-Overview.pdf. Accessed November 29, 2022. 2. Kumar S, et al. Lancet Oncol. 2016;17(8):e328-e346.
3. Mateos MV, et al. Hemasphere. 2018;3(1):e163.
Treatment decisions become increasingly complex in RR MM MM treatments consist of different classes of therapies1,2
• Multi-drug regimens preferred, unless poor PS2 (IMiD, PI and/or mAb, corticosteroid)
Immunomodulatory Drugs (IMiDs)

Proteasome Inhibitors (PIs)
• Effect of myelotoxicity from induction regimens on HSPC collection should be considered3
• Options largely dictated by patient factors and type and response to prior regimens1,4
• Increasingly limited treatment options as patients are refractory to more therapies5
Monoclonal Antibodies (mAbs)
Novel Mechanism of Action (MOA) Drugs
• Clinical trials may be considered4
1L=first line; 2L=second line; 3L=third line; 4L=fourth line; HSPC=hematopoietic stem and progenitor cells; MM=multiple myeloma; PS=performance status; RR=relapsed/refractory.
2020;10(9):94.
. 2019;41(4):285-291.
1. Rajkumar SV, et al. Blood Cancer J. 2. Branagan A, et al. JCO Oncol Pract. 2020;16(1):5-14. 3. Figueiredo A, et al. Hematol Transfus Cell Ther 4. Moreau P, et al. Lancet Oncol. 2021;22(3):e105-e118. 5. Hernández-Rivas JÁ, et al. Biomark Res. 2022;10(1):1.Idecabtagene
Ciltacabtagene
Daratumumab, Carfilzomib, Lenalidomide and Dexamethasone (Dara-KRd), Autologous Transplantation and MRD Response-Adapted Consolidation and Treatment Cessation-Final Primary Endpoint Analysis of the MASTER Trial
Luciano J. Costa1, Saurabh Chhabra2, Natalie S. Callander, MD3 , Eva Medvedova4, Bhagirathbhai Dholaria5, Rebecca Silbermann4, Kelly Godby1, Binod Dhakal2, Susan Bal1, Smith Giri1, Anita D’Souza2, Timothy Schmidt3, Aric
COMMIT- Academic Consortium to Overcome Multiple Myeloma through Innovative Trials
 Hall3, Pamela Hardwick1, Robert F. Cornell5, Parameswaran Hari2
1- University of Alabama at Birmingham; 2- Medical College of Wisconsin; 3- University of Wisconsin at Madison; 4- Oregon Health and Science University; 5- Vanderbilt University
Hall3, Pamela Hardwick1, Robert F. Cornell5, Parameswaran Hari2
1- University of Alabama at Birmingham; 2- Medical College of Wisconsin; 3- University of Wisconsin at Madison; 4- Oregon Health and Science University; 5- Vanderbilt University
Dara-KRd
• Daratumumab 16 mg/m2 days 1,8,15,22 (days 1,15 C 3-6; day 1 C >6)




• Carfilzomib (20) 56 mg/m2 Days 1,8,15
• Lenalidomide 25 mg Days 1-21
• Dexamethasone 40mg PO Days 1,8,15,22
MRD assessment by NGS
*24 and 72 weeks after completion of therapy
MASTER trial
”MRD-SURE” -Treatment-free observation and MRD surveillance*


• NGS-MRD response-adapted therapy is feasible in ~96% of patients in multi center setting – 72% reaching MRD-SURE.
• Patients with standard and high-risk NDMM have similar depth of response and low risk of MRD resurgence or progression when treated with Dara-KRd/AHCT and MRDadapted treatment cessation.
• Quadruplet therapy and achievement of confirmed MRD (-) responses enables the exploration of treatment cessation and “MRD-SURE” as alternative to continuous therapy.
Effective novel consolidative strategies should be explored to clear MRD and improve outcomes in patients with ultra-high-risk MM
Sequential Therapy in Multiple Myeloma Guided by MRD Assessments
Quadruplet x 6 cycles













Intensification
MRD (-) randomization MRD (+) randomization







Quadruplet X 3 cycles CD38MoAb-R X3 cycles
T-cell Redirecting therapy
AHCT AHCT ← MRD1x → Consolidation Arm M ← MRD2 →
T-cell Redirecting therapy
• Multiple myeloma is becoming more common
• Multiple myeloma is a complex disease
• Multiple myeloma is preceded by 2 conditions MGUS and SMM
• Multiple myeloma can behave differently based on disease characteristic and stage.
• Depth of response matter. Getting rid of myeloma equal better survival








Mary Steinbach, DNP, APRN
Huntsman Cancer Institute-University of Utah
COLOR WHEEL OF TREATMENT


Myeloma treatment
Infection and Side Effect Management
Know your care team, Telehealth & Meeting Prep, & Shared Decision Making

• Rapid and effective disease control


• Durable disease control

• Minimize side effects
• Allow for good quality of life
• Improved overall survival
• Prevent disease- and treatmentrelated side effects
• Optimize symptom management

• Allow for good quality of life
DISCUSS GOALS AND PRIORITIES WITH YOUR HEALTHCARE TEAM
You are central to the care team








Be empowered
• Ask questions, learn more
• Participate in decisions
Communicate with your team
• Understand the roles of each team member and who to contact for your needs

• Participate in support network








Be empowered to be part of the treatment decision-making

• Ask for time to consider options (if needed/appropriate)
• Understand options; consider priorities
• Use reliable sources of information
• Use caution considering stories of personal experiences
• Consider your goals/values/preferences
• Express your goals/values/preferences; create a dialog


• My top priority is [goal/value]; additional [preferences] are also important.
• I think [treatment] may be a good choice given my priorities… What do you think?
• Arrive at a treatment decision together

Come prepared:
• Bring a list of current medications, prescribed and over the counter
• Write down your questions and concerns. Prioritize them including financial issues

• Have there been any medical or life changes since your last visit?
• Current symptoms - how have they changed (improved, worsened, stable)? Keep a symptom diary. Bring it along
• Communicate effectively: your health care team can’t help if they don’t know
• Know the “next steps”, future appointments, medication changes, refills, etc
Check with your healthcare team –Is telemedicine an option?
Similar planning for “in-person” appointment PLUS:
• What is the process and what technology is needed?

• Plan your labs: are they needed in advance? Do you need an order?
• Plan your location: quiet, well-lit location with strong wi-fi is best
• Plan yourself: consider if you may need to show a body part and wear accessible clothing
• Collect recent vital signs (blood pressure, temp, heart rate) self-serve blood pressure cuff is available at many pharmacies and for purchase
Transplant
Eligible Patients
Transplant
Ineligible patients
Initial Therapy
Transplant
Consolidation
Maintenance
Treatment of Relapsed disease
Everyone
Consolidation/ Maintenance/ Continued therapy
Supportive Care

• There are no black and white answers to deciding to undergo a transplant
• Undergoing transplant is a commitment for both you and your care partner
• Understanding the process will help bring to focus elements needed to decide if/when to undergo transplant

Clinical Experience Data from Research
Patient Preference
Adapted from Philippe Moreau, ASH 2015



CRS is a common but usually mild side effect

Headache
Encephalopathy
Confusion
Seizures
Tremors
NEUROTOXICITY
Altered wakefulness
Neurotoxicity is a rare but serious side effect
Hallucinations
Facial nerve palsy
Ataxia Apraxia
CRS = cytokine release syndrome; ICANS = immune effector cell–associated neurotoxicity syndrome; ICE = Immune Effector Cell Encephalopathy screening tool; MRI = magnetic resonance imaging.
Brudno JN, Kochenderfer JN. Blood. 2016;127(26):3321-3330. Lee DW, et al. Biol Blood Marrow Transplant. 2019;25:625-638.

A meta-analysis identified the most common patient -reported symptoms and impact on QOL, and were present at all stages of the disease. Symptoms resulted from both myeloma disease and treatment, including transplant, and were in these categories:
Physical
• Fatigue
• Constipation
• Pain
• Neuropathy

• Impaired Physical Functioning
• Sexual Dysfunction


Psychological
• Depression
• Anxiety
• Sleep Disturbance
• Decreased Cognitive Function
• Decreased Role & Social Function

Financial
• Financial burden (80%)
• Financial toxicity (43%)
All can affect quality of life and relationships
• Fatigue is the most common reported symptom (98.8%)
Sources include anemia, pain, reduced activity, insomnia, treatment toxicity, bone marrow suppression


• Anxiety reported in >35%


• Depression nearly 25% Financial concerns, disease progression, end-of-life, and change in social and sexual function were highlighted sources
Often, people do not share these symptoms with their provider. Talk to your provider about symptoms that are not well controlled or thoughts of self harm. Help is available.
&
Steroid Synergy
Steroids are a backbone and work in combination to enhance myeloma therapy
• Consistent schedule (AM vs. PM)

• Take with food
• Stomach discomfort: Over-the-counter or prescription medications

• Medications to prevent shingles, thrush, or other infections
Steroid Side Effects
• Irritability, mood swings, depression
• Difficulty sleeping (insomnia), fatigue
• Increased risk of infections, heart disease
• Muscle weakness, cramping
• Increase in blood pressure, water retention
Rajkumar
• Blurred vision, cataracts
• Flushing/sweating
• Stomach bloating, hiccups, heartburn, ulcers, or gas
• Weight gain, hair thinning/loss, skin rashes
• Increase in blood sugar levels, diabetes

SV, Jacobus S, Callander NS, Fonseca R, Vesole DH, Williams ME, Abonour R, Siegel DS, Katz M, Greipp PR, Eastern Cooperative Oncology Group (2010) Lenalidomide plus highdose dexamethasone versus lenalidomide plus low -dose dexamethasone as initial therapy for newly diagnosed multiple myeloma: an open-label randomised controlled trial. Lancet Oncol 11(1):29–37.
T, Faiman B. Steroid-Associated Side Effects: A Symptom Management
Diarrhea may be caused by medications and supplements
• Laxatives, antacids with magnesium
• Antibiotics, antidepressants, others
• Milk thistle, aloe, cayenne, saw palmetto, ginseng
• Sugar substitutes in sugar free gum
Avoid caffeinated, carbonated, or heavily sugared beverages
Take anti-diarrheal medication
• Imodium®, Lomotil ®, or Colestid if recommended
• Fiber binding agents – Metamucil®, Citrucel®, Benefiber®
• Welchol ® if recommended
Constipation may be caused by
• Opioid pain relievers, antidepressants, heart or blood pressure medications, others
• Supplements: Calcium, Iron, vitamin D (rarely), vitamin B-12 deficiency
Increase fiber
• Fruits, vegetables, high fiber whole grain foods
• Fiber binding agents – Metamucil®, Citrucel®, Benefiber®

Fluid intake can help with both diarrhea and constipation, and good for kidneys. Discuss GI issues with health care providers to identify causes and make adjustments to medications and supplements.

Pain can significantly compromise quality of life

Sources of pain include bone disease, neuropathy and medical procedures
Management
• Prevent pain when possible
• Bone strengtheners to decrease fracture risk; anti viral to prevent shingles; sedation before procedures
• Interventions depends on source of pain
• Monitor serum calcium levels
• Imaging may be needed depending on type and location of pain (eg, MRI, PET-CT)
• May include medications (eg bone modifying agents), activity, surgical intervention, radiation therapy, etc

• Complementary therapies (Mind-body, medication, yoga, supplements, acupuncture, etc)
Tell your health care provider about any new bone pain or chronic pain that is not adequately controlled
Peripheral neuropathy: damage to nerves in extremities (hands, feet, or limbs)
• Numbness
• Tingling
• Prickling sensations
• Sensitivity to touch
• Burning and/or cold sensation
• Muscle weakness
Prevention / management:
• Bortezomib once-weekly or subcutaneous administration
• Massage area with cocoa butter regularly
• Supplements:
• B-complex vitamins (B1, B6, B12)
• Folic acid, and/or amino acids but do not take on day of Velcade® (bortezomib) infusion
• Safe environment: rugs, furnishings, shoes


If PN worsens, your HCP may:
• Change your treatment
• Prescribe oral or topical pain medication
• Suggest physical therapy
Report symptoms of peripheral neuropathy early to your health care provider; nerve damage from PN can be permanent if unaddressed
7-10 fold increased risk of bacterial and viral infections for people with myeloma
• Report fever of more than 100.4°F, shaking chills even without fever, dizziness, shortness of breath, low blood pressure to HCP as directed.
• Compromised immune function comes from multiple myeloma and from treatment.
• Infection is serious for myeloma patients!




Infection Prevention Tips
Good personal hygiene (skin, oral)
Environmental control (wash hands, avoid crowds and sick people, etc)
Growth factor (Neupogen [filgrastim])

Immunizations (NO live vaccines)
Medications (antibacterial, antiviral)
As recommended by your health care team
COVID: The Best Way to Prevent Illness Is to Avoid Being Exposed to the Virus
Spread mainly through respiratory droplets that are produced by cough, sneezing and talking. More droplets with louder talking, yelling, singing

• Get COVID Vaccine + Booster: Excellent protection against severe disease, but vaccine effectiveness may be lower in people with compromised immune systems
• Wear a High-quality Mask: Respiratory droplets can spread disease; a high-quality mask can prevent exposure to airborne viral particles
• Avoid Crowds & Sick People
• Physical Distance & Outdoors: Close contact and indoor locations increases risk of spread
• Wash Your Hands: Less common to get from a hard surface
Manage stress
• Rest, relaxation, sleep hygiene
• Mental health / social engagement

• Complementary therapy
Maintain a healthy weight
• Nutrition
• Activity / exercise
Preventative health care
• Health screenings, vaccinations
• Prevent falls, injury, infection
• Stop smoking
• Dental care
Maintain renal health
• Myeloma management
• Hydration
• Avoid renally-toxic medications
– Dose adjust to renal function
• Diabetes management
Protect your bones
• Nutrition, Calcium + D supplement
• Weight-bearing activity / walking
• Bone strengthening agents
Faiman B, et al. CJON. 2017;21(5)suppl:19-36. Dimopoulous M, et al. Leukemia. 2009;23(9):1545-56. Brigle K, et al. CJON. 2017;21(5)suppl:60-76. Faiman B, et al. CJON. 2017;21(5)suppl:19-36. Faiman B, et al. CJON. 2011;15suppl:66-76. Miceli TS, et al. CJON. 2011;15(4)suppl:9-23.
“An ounce of prevention is worth a pound of cure.” Benjamin Franklin
Financial burden comes from
• Medical costs
• Premiums
• Co-payments

• Travel expenses
• Medical supplies

• Prescription costs
• Loss of income
• Time off work or loss of employment
• Caregiver time off work
Contact the Social Services department at your hospital or clinic to talk to a social worker for assistance.
Funding and assistance may be available
• Federal programs
• Pharmaceutical support
• Non-profit organizations
• Websites:
• Medicare.gov
• SSA.gov
• LLS.org
• Rxassist.org
• NeedyMeds.com
• HealthWellFoundation.org
• Company-specific website
Care partner support is essential for the entire transplant and CAR T processes particularly
• Sedated procedures; Education sessions
• Assistance with daily activities, managing medications and alerting the medical team of changes
• Continued support and assistance is often needed in the early days after returning home. Less assistance will be needed as time goes on.



Care partner can be one person or a rotation of many people.













































• Review the importance of DEPTH of response in early treatment of myeloma and the increasing use of MRD testing
• Discuss emerging approaches in transplant eligible patients, including quadruplet therapy and stem cell transplantation
• Outline the approach to a patient not going to transplant and how to optimize continuous therapy


Partial response


50% reduction in M protein
Very good partial response
90% reduction in M protein
immunofixation positive only

Complete remission
No M-protein
immunofixation negative


Minimal Residual Dis
Minimal Residual Dis


Next Generation Molecular testing

MRD refers to the persistence of residual tumor cells after treatment and is responsible for relapse1

Current techniques can detect MRD with a sensitivity of 10-6 for MM cells2
MR, minimal response; neg, negative; pos, positive; R, relapse
1. Adapted from Hauwel M, Matthes T. Swiss Med Wkly 2014:144:w13907
2. Biran N, et al. Curr Hematol Malig Rep 2014;9:368–78



Newly Diagnosed MM and Risk Stratified
Factors to be considered for ASCT
Age, performance status (PS), comorbidities (R-MCI score, HCT-Cl) and organ function
ASCT Eligible
ASCT Ineligible
1. Most patients will be given a combination of drugs to control the disease quickly
2. We don’t “save the best for last” because early therapies have a long term effect on survival
3. We seek a DEEP and DURABLE response
4. We mix and match from the 3 major classes of drugs and add steroids:
Proteasome Inhibitors – most often botezomib (Velcade)
Immunomodulatory Drugs – lenalidomide (Revlimid)
Monoclonal Antibodies – daratumumab (Darzalex)
5. We decide early on whether or not someone will have a stem cell transplant
Induction
• Velcade/Revlimid/Dex:(VRD)
• Velcade/Thalomid/Dex:(VTD)
• Velcade/Cytoxan/Dex:(CyBorD)
• Darzalex/Revlimid/Dex:(DRD)
• Darzalex/Velcade/Melphalan/Dex
• Darzalex/Velcade/Thalidomide/Dex
• Kyprolis/Revimid/Dex(KRD)
• Darzalex/Velcade/Revlimid/Dex: Dara-RVD
• Ninlaro/Revimid/Dex(IRD)
• Clinical trials
Consolidation
Maintenance
• Stem Cell Transplant

• Continue Induction
• Clinical trial
• Revlimid
• Velcade
• Ninlaro
• Observation
• Thalidomide
• Revlimid/Dara
• Clinical trial
Dara+Pomalyst+Dex
Kyprolis+Pomalyst+Dex
Cytoxan+Pomalyst+Dex
Ninlaro+Pomalyst+Dex
Elo+Pomalyst+Dex
Elo+Thaliomide+Dex
Dara+Kyprolis+Dex
Kyprolis+Revlimid+Dex
Elo+Revlimid+Dex
Dara+Revlimid+Dex
Dara+Velcade+Dex
Elo+Velcade+Dex

Cytoxan+Kyprolis+Thalidomide+dex
4 drug therapies of novel agents
Ninlaro+Cytoxan+Dex
Velcade+ Cytoxan+Dex
Velcade+ Pomalyst+Dex
Chemotherapy

Selinexor+Dex
Selinexor+Velcade
Selinexor+ Dara
Isatuximab(Sarclisa)+




Pomalyst+Dex
Darzalex Faspro (under skin)
Ide-cel CAR-T (FDA approved 3/26/2021)

Cilta-cel CAR-T (FDA approved 2/28/2022)
Teclistamab (FDA approved 10/25/2022)
Lenalidomide maintenance 13 cycles (10-15 mg/d)

Median follow up 89.8 months
HR (95CI) 0.70 [0.59;0.83]
Median PFS 47.3 months (Transplantation, arm B)

Median PFS 35 months (RVD alone, arm A)
30% reduction in the risk of progression or death in patients receiving transplant

Median follow up 89.8 months

HR (95CI) 1.03 [0.8;1.32]
8y-OS 62.2% (Transplantation, arm B)
8y-OS 60.2% (RVD alone, arm A)
More than 60% of the patients in the two arms are alive after 8 years of follow-up

-Patients aged 18-65 yrs with symptomatic newly diagnosed MM following 1 cycle of RVD -56 sites within the United States from 2010 to 2018
End Points of Study and Follow -up
• Primary end point: progression-free survival (time to next relapse)
• Secondary end points included:
• Response rates, overall survival, quality of life, and adverse events
• Follow-up on participant status : median of 6 years

Data cut off:12/12/21
*p-value adjusted using Bonferroni’s correction to control overall family-wise error rate for secondary outcomes


• ASCT remains very relevant and important in prolonging PFS in younger and eligible patients
• BUT it may not be mandatory in all eligible patients upfront
• As with other agents, we INDIVIDUALIZE the sequencing patterns
• ASCT does carry genuine toxicity, short term and long term
• We may become callous to these toxicities
• Maintenance therapy remains an important part of myeloma therapy
Daratumumab (DARA) + Lenalidomide, Bortezomib, and Dexamethasone (RVd) in Patients With Transplant-eligible Newly Diagnosed Multiple Myeloma (NDMM): Final Analysis of GRIFFIN
Douglas W. Sborov,1 Jacob Laubach,2 Jonathan L. Kaufman,3 Brandi Reeves,4 Cesar Rodriguez,5
Ajai Chari,5 Rebecca Silbermann,6 Luciano J. Costa,7 Larry D. Anderson Jr.,8 Nitya Nathwani,9
Nina Shah,10 Naresh Bumma,11 Sarah A. Holstein,12 Caitlin Costello,13 Andrzej Jakubowiak,14
Robert Z. Orlowski,15 Kenneth H. Shain,16 Andrew J. Cowan,17 Huiling Pei,18 Annelore Cortoos,19
Sharmila Patel,19 Thomas S. Lin,19 Paul Richardson,2 Saad Z. Usmani,20 Peter M. Voorhees21
1Huntsman Cancer Institute, University of Utah School of Medicine, Salt Lake City, UT, USA; 2Dana-Farber Cancer Institute, Harvard Medical School, Boston, MA, USA; 3Winship Cancer Institute, Emory University, Atlanta, GA, USA; 4University of North Carolina – Chapel Hill, Chapel Hill, NC, USA; 5Icahn School of Medicine at Mount Sinai, New York, NY, USA; 6Knight Cancer Institute, Oregon Health & Science University, Portland, OR, USA; 7University of Alabama at Birmingham, Birmingham, AL, USA;
8Department of Internal Medicine, Division of Hematology/Oncology, UT Southwestern Medical Center, Dallas, TX, USA; 9Judy and Bernard Briskin Center for Multiple Myeloma Research, City of Hope Comprehensive Cancer Center, Duarte, CA, USA; 10Department of Medicine, University of California San Francisco, San Francisco, CA, USA; 11Division of Hematology, The Ohio State University Comprehensive Cancer Center, Columbus, OH, USA; 12University of Nebraska Medical Center, Division of Oncology and Hematology Department of Internal Medicine, Omaha, NE, USA; 13Moores Cancer Center, University of California San Diego, La Jolla, CA, USA; 14University of Chicago Medical Center, Chicago, IL, USA; 15Department of Lymphoma/Myeloma, The University of Texas MD Anderson Cancer Center, Houston, TX, USA; 16Department of Malignant Hematology, H. Lee Moffitt Cancer Center, Tampa, FL, USA; 17Division of Medical Oncology, University of Washington, Seattle, WA, USA; 18Janssen Research & Development, LLC, Titusville, NJ, USA; 19Janssen Scientific Affairs, LLC, Horsham, PA, USA; 20Memorial Sloan Kettering Cancer Center, New York, NY, USA; 21Levine Cancer Institute, Atrium Health, Charlotte, NC, USA
Presented at the 19th International Myeloma Society (IMS) Annual Meeting; August 25-27, 2022; Los Angeles, CA, USA.
Scan the QR code.

https://www.congresshub.com/Oncology/IMS20
22/Daratumumab/Sborov
The QR code is intended to provide scientific information for individual reference, and the information should not be altered or reproduced in any way.
sCR, P= 0.0079a

≥CR, P= 0.0005a
• Rates of ≥CR improved over time and the deepest responses occurred at the end of study maintenance
• At all timepoints, response rates for D-RVd were consistently higher versus RVd
PR, partial response; SD/PD/NE, stable disease/progressive disease/not evaluable. a P value was calculated using the Cochran–Mantel–Haenszel chi-squre test. bResponse rates are from the primary analysis cutoff (median follow-up: 13.5 months), and the response-evaluable population included 196 patients (D-RVd, n = 99; RVd, n = 97). cResponse rates for the maintenance phase were evaluated at the time of final analysis (median follow-up: 49.6 months), and the response-evaluable population included 198 patients (D-RVd, n = 100; RVd, n = 98).
• Median follow-up: 49.6 months
• Median PFS was not reached in either group
• PFS was longer for D-RVd/DR versus RVd/R, with a clinically meaningful 55% reduction in the risk of disease progression or death
• The separation of the PFS curves occurred beyond 1 year of maintenance
HR, 0.45 (95% CI, 0.21-0.95)

P = 0.0324
aHR and 95% CI from a Cox proportional hazards model with treatment as the sole explanatory variable and stratified with ISS staging (I, II, III) and baseline creatinine clearance (CrCl [30-50 mL/min or >50 mL/min]) at randomization. A hazard ratio <1 indicates an advantage for D-RVd. P-value is based on the log-rank test stratified with ISS staging and baseline creatinine clearance at randomization.

Induction phase (3 x 6-week cycles)
Maintenance phase (4-week cycles)
ASCT, autologous stem cell transplant; D, day; d/Dex, dexamethasone; HDT, high-dose therapy; Isa, isatuximab; IV, intravenous; NDMM, newly diagnosed multiple myeloma; PD, progressive disease; PO, oral; R/Len, lenalidomide; SC, subcutaneous; Te, transplant eligible; V/Bor, bortezomib; RVd is off label use in some countries according to the lenalidomide summary of product characteristics. 1. ClinicalTrials.gov: NCT03617731

Patients with MRD negativity at the end of induction therapy
OR 1.83 (95% CI 1.34–2.51)
Low number of not assessable/missing† MRD status: Isa-RVd (10.6%) and RVd (15.2%)
Isa-RVd is the first regimen to demonstrate a rapid and statistically significant benefit from treatment by reaching a MRD negativity of 50.1% at the end of induction and to show superiority vs. RVd in a Phase 3 trial

*P value derived from stratified conditional logistic regression analysis
†Missing NGF-MRD values were due to either patients’ loss to follow-up during induction therapy or to missing bone marrow samples or technical failures in measurement counted as non-responders, i.e. NGF-MRD positive

confidence interval; d, dexamethasone; Isa, isatuximab; ITT, intent-to-treat; MRD, minimal residual
NGF, next-generation flow; OR, odds ratio; R, lenalidomide; V, bortezomib
First primary endpoint, end of induction MRD negativity by NGF (10-5), was met in ITT analysis
Dara-KRd
• Daratumumab 16 mg/m2 days 1,8,15,22 (days 1,15 C 3-6; day 1 C >6)




• Carfilzomib (20) 56 mg/m2 Days 1,8,15
• Lenalidomide 25 mg Days 1-21
• Dexamethasone 40mg PO Days 1,8,15,22
MRD assessment by NGS
”MRD-SURE” -Treatment-free observation and MRD surveillance*


• We are transitioning to quadruplets in frontline eligible patients
• BUT the optimal length of a quadruplet is still to be determined!
• Transplant still has a role in MM even with long term use of novel agents
• Consolidation therapy may deepen responses and should be considered in patients who have not achieved VGPR
• MRD guided discontinuation may be possible in lower risk groups but not high risk patients
Recommendation
Patients should be referred to a transplant center to determine transplant eligibility
Evidence Rating
Type: Evidence based
Evidence quality: Intermediate, benefit outweighs harm
Strength of recommendation: Moderate
Chronologic age and renal function should not be the sole criteria used to determine eligibility for SCT.
Type: Evidence based
Evidence quality: Intermediate, benefit outweighs harm
Strength of recommendation: Moderate




IMWG score of 1 = Intermediate-Fit
3-year OS was 76% (HR=1.61; 95% CI 1.02-2.56; p=.042)
Toxicities 16.7% (HR 1.23, 95% CI 0.89-1.71; p=.217) and
Palumbo
A Blood Engelhardt M. Haematologica

‒ Patients were enrolled in MAIA from March 2015 through January 2017
D: 16 mg/kg IV
Key eligibility criteria
• TIE NDMM
• ECOG PS score 0-2
• CrCl
≥30 mL/min
MAIA
TIE,
BMI,
aOn
QW Cycles 1-2, Q2W Cycles 3-6, then Q4W thereafter until PD
R: 25 mg PO Days 1-21 until PD
da: 40 mgb PO or IV Days 1, 8, 15, 22 until PD
Primary endpoint
• PFS
Rd
R: 25 mg PO Days 1-21 until PD
d: 40 mg PO Days 1, 8, 15, 22 until PD
D-Rd Cycles: 28 days
End-oftreatment visit (30 days after last dose)
Longterm follow-up
Key secondary endpoints
• OS
• PFS2
• ORR
• CR/sCR rate
• MRD (NGS; 10–5) 1:1 randomisation

transplant-ineligible; ECOG PS, Eastern Cooperative Oncology Group performance status; CrCl , creatinine clearance; IV, intravenous; QW, once weekly; Q2W, once every 2 weeks; Q4W, once every 4 weeks; PD, progressive disease; PO, oral; ORR, overall response rate; CR, complete response; sCR, stringent complete response; MRD, minimal residual disease; NGS, next-generation sequencing;
body mass index.
days when DARA is administered, dexamethasone will be administered to patients in the D-Rd arm and will serve as the treatment dose of steroid for that day, as well as the required pre-infusion medication. bFor patients >75 years of age or with BMI <18.5 kg/m2, dexamethasone was administered at a dose of 20 mg QW.
is a multicentre, randomised, open-label, active-controlled, phase 3 study of D-Rd versus Rd alone in patients with NDMM who are transplant ineligible
Demographics and baseline characteristics were well balanced between arms

• D-Rd induced deeper responses with significantly higher rates of ≥CR and ≥VGPR, compared with Rd

• With >28 months of additional follow -up, responses deepened with continued DARA therapy
very good partial response; PR, partial response.
• D-Rd continued to demonstrate a significant PFS benefit, with median PFS not reached with D-Rd
• These data provide a new PFS benchmark in patients with NDMM who are transplant ineligible

HR, 0.68; 95% CI, 0.53-0.86;
D-Rd demonstrated a significant benefit in OS, with a 32% reduction in the risk of death, in patients with NDMM who are transplant ineligible

• Although ASCT remains the standard of care, use is likely to decline in patients who are 65-75 or with significant comorbidities
• Continuous therapy has resulted in better outcomes

• The balance of toxicity and efficacy is particularly important in this population
• ESPECIALLY with dexamethasone
• Most common approach is to select 2 agents from the 3 Novel Classes (PIs, IMiDs and MoAbs)
• Most will use DRD in standard risk patients
• Some may favor VRD in certain high risk patients
• DRD is more easily delivered and feasible
• D-VRD may well be a future standard of care even in these patients
Panobinostat
Idecabtagene
Ciltacabtagene






11:55 AM – 12:40 PM LUNCH BREAK 12:40 –
PM Local Patient & Care Partner Panel
Annie Taussig, Patient Advocate and John Taussig, Care Partner 1:00 –

PM Q&A 1:10 –
PM Maintenance Therapy
Andrew Cowan, MD – University of Washington 1:30 –
PM Q&A 1:40 – 2:25 PM Relapsed Therapies & Clinical Trials

Rafat Abonour, MD – University of Indiana
–
–














• Discuss the principle of consolidation therapy and its application in myeloma

• Outline the major options for maintenance therapy
• Introduce the newer trend for the use of dual maintenance
• Provide an algorithm for maintenance based on risk status
• Induction: Intense and short term therapy with goal to achieve rapid remission

• Consolidation: Intense and shorter term therapy with goal of deep remission
• Maintenance: Less intense longer term therapy with goal of better PFS and OS
What does the Ideal Maintenance therapy look like?
• Deepen remission
• Prolong remission
• Easy to administer
• Minimal toxicity
Meta-Analysis of Lenalidomide Maintenance after ASCT
CALGB 100104 (accrual 8/2005 – 11/2009)
INDUCTION
ASCT
1:1 RANDOMIZATION
“NO EVIDENCE OF PD”
Primary Endpoint: PFS
IFM 2005-02 (accrual 6/2006 – 8/2008)
INDUCTION
ASCT
1:1 RANDOMIZATION
“NO EVIDENCE OF PD”
Primary Endpoint: PFS
LEN: 2 COURSES
GIMEMA (RV-MM-PI-209) (accrual 11/2007 – 7/2009)
LEN + DEX × 4 INDUCTION
Primary Endpoint: PFS
ASCT
MPR: 6 COURSES
LEN MNTCa (n = 231) PLACEBO (n = 229)
LEN MNTCa (n = 307) PLACEBO (n = 307)
LEN MNTCb (n = 67) NO TREATMENT (n = 68)
PRIMARY
Target population of patients with NDMM who received LEN maintenance or placebo/no maintenance after ASCT
a Starting dose of 10 mg/day on days 1-28/28 was increased to 15 mg/day if tolerated and continued until PD.
b Patients received 10 mg/day on days 1-21/28 until PD.
ASCT, autologous stem cell transplant; LEN, lenalidomide; NDMM, newly diagnosed multiple myeloma; MNTC, maintenance; MPR, melphalan, prednisone, and Len; PD, progressive disease.
Attal et al ASCO 2016; McCarthy et al EHA 2016



 McCarthy et al. J Clin Oncol. 2017, 35:3279-3289.
McCarthy et al. J Clin Oncol. 2017, 35:3279-3289.


 McCarthy et al. J Clin Oncol. 2017, 35:3279-3289.
McCarthy et al. J Clin Oncol. 2017, 35:3279-3289.
3 randomized trials: 1,209 patients:
• Median follow up 6.6 years
• PFS 52.8 months for lenalidomide vs 23.5 in placebo

• PFS2 also prolonged 73.3 months vs 56.7 (ie not creating more aggressive clone)
• Median overall survival: 86 months v. not reached: P = 0.001
• Benefit for ≤ PR as well as VGPR/CR patients
• 29% discontinuation rate with lenalidomide
• Second primary malignancy rate higher at 6.1% vs 2.8% in placebo after PD
Induction
NDMM
N=1551 (TE=828; TNE=723)
Maintenance
Lenalidomide
10 mg/day, days 1‒21/28
R 1:1
Observation
Median follow -up: 27 months (IQR 13‒43)
Exclusion criteria
• Failure to respond to lenalidomide as induction IMiD, or development of PD
• Previous or concurrent active malignancies
Treated on Myeloma XI induction protocols IQR, interquartile range; NDMM, newly diagnosed multiple myeloma;

Significant improvement in PFS from 18 to 36 months, HR=0.45



4x KCd
K: 36^ mg/m2 d 1-2,8-9,15-16
C: 300 mg/m2 d 1,8,15
d: 20 mg. d 1-2,8-9,15-16,22-23
4x KRd
K: 36^ mg/m2 d 1-2,8-9,15-16
R: 25 mg d 1-21
d: 20 mg. d 1-2,8-9,15-16,22-23
Intensification with high-dose melphalan followed by autologous stem-cell reinfusion MOBILIZATION
4x KRd
K: 36^ mg/m2 d 1-2,8-9,15-16
R: 25 mg d 1-21
d: 20 mg. d 1-2,8-9,15-16,22-23
4x KRd
K: 36 mg/m2 d 1-2,8-9,15-16
R: 25 mg d 1-21
d: 20 mg. d 1-2,8-9,15-16,22-23
4x KCd
K: 36 mg/m2 d 1-2,8-9,15-16
C: 300 mg/m2 d 1,8,15
d: 20 mg. d 1-2,8-9,15-16,22-23
4x KRd
K: 36 mg/m2 d 1-2,8-9,15-16
R: 25 mg d 1-21
d: 20 mg. d 1-2,8-9,15-16,22-23
R: 10 mg days 1-21, until progression or intolerance
K: 36 mg/m2 d 1, 2, 15, 16 up to 2 years*
R: 10 mg days 1-21, until progression or intolerance
K: 36 mg/m2 d 1-2,8-9,15-16
R: 25 mg d 1-21
d: 20 mg. d 1-2,8-9,15-16,22-23
^20 mg/m 2 on days 1-2, cycle 1 only. *Carfilzomib 70 mg/m 2 days 1, 15 every 28 days up to 2 years for patients that have started the maintenance treatment from 6 months before the approval of Amendment 5.0 onwards.
NDMM, newly diagnosed multiple myeloma, R1, first randomization (induction/consolidation treatment); R2, second randomization (maintenance treatment); ASCT, autologous stem -cell transplantation; K, carfilzomib; R, lenalidomide; C, cyclophosphamide; d, dexamethasone; KCd_ASCT, KCd induction-ASCT-KCd consolidation; KRd_ASCT, KRd induction-ASCT-KRd consolidation; KRd12, 12 cycles of KRd.
KRd_ASCT vs. KRd12 vs. KCd_ASCT KR vs. R
Median follow-up from Random 2: 37 months (IQR 33‒42)
KRd_ASCT vs. KCd_ASCT : HR 0.54, 95% CI 0.38-0.78, p<0.001
KRd_ASCT vs. KRd12: HR 0.61, 95% CI 0.43-0.88, p=0.0084
KRd12 vs. KCd_ASCT : HR 0.88, 95% CI 0.64-1.22, p=0.45
KR vs. R: HR 0.64, 95% CI 0.44-0.94, p=0.02294
Median follow-up from Random 1: 51 months (IQR 46‒55) 3-year PFS reported in the figure. Random 1, first randomization (induction/consolidation treatment); ASCT, autologous stem-cell trasplantation; K, carfilzomib; R, lenalidomide; C, cyclophosphamide; d, dexamethasone; KCd_ASCT, KCd induction-ASCT-KCd consolidation; KRd_ASCT, KRd induction-ASCT-KRd consolidation; KRd12, 12 cycles of KRd; Random 2, second randomization (maintenance treatment); p, p-value; HR, hazard ratio; CI, confidence interval.
• It appears that dual maintenance therapy prolongs PFS
• This occurs in both standard risk AND high risk patients
• It further opens the door to other dual maintenance strategies currently being used and explored:
• Lenalidomide + Bortezomib
• Lenalidomide + Ixazomib
• Lenalidomide + Daratumumab
• Others??

• Recall that GRIFFIN gave Dara for 2 years with lenalidomide in maintenance
• Responses continued to deepen with Dara
• CASSIOPEIA randomized pts to no maintenance vs dara q 8 weeks
• Overall there was a benefit to having dara maintenance vs placebo
• However, if dara had been given at induction, that benefit did not seem to continue (ie If you had dara upfront, it didn’t add more to maintenance)
• We just don’t know what benefit it may add to lenalidomide

• Future studies with dara and Isatuximab will guide us
• Until then it is not generally used in this context
Charlotte Pawlyn1,2, Tom Menzies3, Faith Davies4, Ruth de Tute5, Rowena Henderson3, Gordon Cook3,6, Matthew Jenner7, John Jones8, Martin Kaiser1,2, Mark Drayson9, Roger Owen8, David Cairns3, Gareth Morgan4, Graham Jackson10
1) The Institute of Cancer Research, London, UK; 2) The Royal Marsden Hospital, London, UK; 3) Clinical Trials Research Unit, Leeds Institute of Clinical Trials Research, University of Leeds, Leeds, UK; 4) Perlmutter Cancer Center, NYU Langone Health, New York, US; 5) HMDS, Leeds Cancer Centre, Leeds Teaching Hospitals NHS Trust, Leeds, United Kingdom; 6) Leeds Cancer Centre, Leeds Teaching Hospitals NHS Trust, Leeds, UK; 7) University Hospital Southampton NHS Foundation Trust, Southampton, UK; 8) Kings College Hospital NHS Foundation Trust, London, UK; 9) Institute of Immunology and Immunotherapy, University of Birmingham, Birmingham, UK; 10) Department of Haematology, University of Newcastle, Newcastle- upon-Tyne, UK
On behalf of the Myeloma XI Trial Management Group and NCRI Haem-Onc Clinical Studies Group


Defining the optimum duration of lenalidomide maintenance after autologous stem cell transplant – data from the Myeloma XI trial.
N=1248
Median follow up: 44.7 months (IQR 32.4-62.7)
Median duration of lenalidomide therapy 28 cycles (range 1-96)
• Patients still on therapy 330/730 (45%)

• These data suggest an ongoing PFS benefit associated with continuing lenalidomide maintenance beyond at least 4-5 years in the overall patient population
• Even in patients with sustained MRD negativity, there is evidence of benefit from continuing lenalidomide maintenance for at least 3 years in total
• Randomised trials to address the impact of stopping lenalidomide maintenance in patients with sustained MRD negativity could be considered, at no earlier than 3 years
• In patients who are MRD +ve these data support continuing lenalidomide until disease progression
• No evidence of cumulative haematological toxicity was identified
• These findings emphasise the need for long term follow up of maintenance studies to enable the exploration of such questions
• There is a planned powered OS update of Myeloma XI in 2023

• Should post-transplant maintenance therapy be recommended for all patients?
• Yes
• Which agent should be used?
• Lenalidomide remains the standard of care
• What is the optimal duration?
• Treatment until progression remains the standard of care
• What should patients with high-risk cytogenetics receive?
• Consider lenalidomide + proteasome inhibitor; clinical trial
• Should MRD status dictate maintenance therapy?
• Not outside of a clinical trial
• What about Second Primary Malignancies?
• They are real, require a discussion and monitoring, but are outweighed by benefit






How Do I Treat Relapsed Multiple Myeloma?

Harry and Edith Gladstein Professor of Cancer Research
Professor of Medicine, Pathology and Laboratory Medicine
Director, Multiple Myeloma, Waldenstrom's Disease and Amyloidosis Program
Indiana University School of Medicine
Rafat Abonour, M.D.When should we treat relapsed disease?
• At biochemical relapse?
• When myeloma protein starts rising!
• When involved free light chain starts rising!
• At Clinical relapse?
• CRAB criteria (Anemia, kidney failure, high calcium or new bone disease)
• Extramedullary disease (myeloma growing at tumors outsides the bone)

When should we treat relapsed disease?
• We do not know, but we can speculate!
• Most approved treatment in relapsed myeloma were based on biochemical relapse.

• Some observations support better outcome when treating biochemical relapse:
• Mayo clinic showed better overall survival when treating biochemical relapse (median PFS 125 vs 81 months)

• Con:
• 25% of biochemical relapse patients will have a smoldering course. No progression for 2 years.
• Pros:
• Median time between biochemical relapse and clinical symptoms is about 5-6 months.
• If you do not get it right at first relapse you may not get it right at subsequent relapses
Proportion of patients receiving treatment at each line of therapy (%)
Active disease Remission Relapse 2 3rd-line: 38%

The proportion of patients receiving treatment decreases with each line of therapy1,2
Median TTP 18 months; 74% CR/VGPR
TTP 7 months; 43% CR/VGPR Relapse 1 2nd-line: 61%
Relapse 3 4th-line: 15%
Over time, MM patients tend to have shorter remissions and lesser responses to standard treatments1,2

First Second Third Fourth Fifth Sixth


• Most patients with MM have multiple distinct subclonal populations as a result of the expansion of genetically different myeloma cells; this causes intratumoral heterogeneity1
• MM is clonally heterogeneous at diagnosis and throughout treament2
• The genomic heterogeneity of MM contributes to treatment resistance and relapse3
• Wide variety of mutations found within a single patient may result in treatment resistance and refractory disease1,3,4
• Furthermore, subclones continually mutate over time, including after treatment, which may contribute to resistance and result in disease progression1,5

• Myeloma cells in each patients are a family of odds and aggressive members

• The longer this family sticks around the odder and more aggressive it becomes
• Family therapy is not going to work, you can not be politically correct here, eradicate them early.
• This is making the case for early treatment and with combination regimen
• Disease burden/stage1
– Bone marrow burden
– CRAB symptoms
– Proliferation markers
• Cytogenetic risk2
– Standard vs high risk
• Type and response to prior therapy2
• Sequencing of treatment options2
• Regimen-related toxicity3
• Reimbursement/access2


• Age2
• Performance status/frailty2
• Comorbidities2
• Bone marrow reserve2
• Patient preferences2
• Eligibility for clinical trial2

• Quality of life3
• Care partner/social support4
There are numerous factors to consider when selecting treatment in MM1-3CRAB=calcium level increase, renal dysfunction, anemia, bone lesions; MM=multiple myeloma.

MM is a collection of several cytogenetically distinct plasma cell malignancies
Cytogenetic abnormalities can influence disease course, response to therapy, and prognosis
Double-hit:
Triple-hit:
importantMM=multiple myeloma; mSMART=Mayo Stratification of Myeloma and Risk-Adapted Therapy. Rajkumar SV. Am J Hematol. 2020;95:548-567
Goals of therapy in MM center around achievement of deep and durable responses while maintaining patient quality of life1,2


Induce remission (a reduction in plasma cells/M-protein to a very low/undetectable level)1,2
Prolong OS1
Aim for a rapid, deep, and durable response1,3

Improve patient’s daily functioning and preserve QoL1



Achieve prolonged PFS3
Minimize adverse events1

MM=multiple myeloma; OS=overall survival; PFS=progression-free survival; QoL=quality of life.
1. Multiple Myeloma Research Foundation. https://themmrf.org/wp-content/uploads/2020/05/MMRF-Treatment-Overview.pdf. Accessed November 29, 2022. 2. Kumar S, et al. Lancet Oncol 2016;17(8):e328-e346.
3. Mateos MV, et al. Hemasphere. 2018;3(1):e163.
Treatment decisions become increasingly complex in RR MM MM treatments consist of different classes of therapies1,2
• Multi-drug regimens preferred, unless poor PS2 (IMiD, PI and/or mAb, corticosteroid)
Immunomodulatory Drugs (IMiDs)


Proteasome Inhibitors (PIs)
• Effect of myelotoxicity from induction regimens on HSPC collection should be considered3
• Options largely dictated by patient factors and type and response to prior regimens1,4
• Increasingly limited treatment options as patients are refractory to more therapies5

Monoclonal Antibodies (mAbs)
Novel Mechanism of Action (MOA) Drugs

• Clinical trials may be considered4
1L=first line; 2L=second line; 3L=third line; 4L=fourth line; HSPC=hematopoietic stem and progenitor cells; MM=multiple myeloma; PS=performance status; RR=relapsed/refractory.
2020;10(9):94.
Ther. 2019;41(4):285-291.
1. Rajkumar SV, et al. Blood Cancer J. 2. Branagan A, et al. JCO Oncol Pract. 2020;16(1):5-14. 3. Figueiredo A, et al. Hematol Transfus Cell 4. Moreau P, et al. Lancet Oncol. 2021;22(3):e105-e118. 5. Hernández-Rivas JÁ, et al. Biomark Res. 2022;10(1):1.Steroids

Conventional Chemo ImIDs
Proteasome Inhibitors
HDAC inhibitor
Prednisone Melphalan Thalidomide Bortezomib Panobinostat
Dexamethasone Cyclophosphamide Lenalidomide Carfilzomib
Doxorubicin Pomalidomide Ixazomib





















































DCEP/D PACE
Immunologic approaches
XPO inhibitor
Daratumumab (anti CD38) Selinexor
Isatuximab (anti CD38)
Elotuzumab (anti CS1)
Belantamab (anti BCMA + MMAF)
ABECMA
Teclistimab
Tecvyli
METRO28
Carmustine
Others: Venetoclax
Bendamustine
How does your oncologist decide what to do?

It is like going to the Cheesecake factory
This is a very short menu



This is not a very short menu
GREAT NEWS WE HAVE OPTIONS
BAD NEWS YOUR DOCTOR MAY GET CONFUSED




Preferred options†:
DRd or KRd
Alternatives‡: DVd, Kd, DKd, Isa–Kd, IRd, Elo–Rd, PVd, or SVd (subject to approval)
If daratumumab, isatuximab, or carfilzomib are not available: Rd, Vd, VTd, VCd, or VMP

Preferred options†: PVd, DKd, or Isa–Kd
*Consider salvage autotransplantation in eligible patients. †Grade of recommendation: 1A. ‡Grade of recommendation: 1B. § Grade of recommendation: 1C.
Alternatives‡: DVd or Kd
Other options§: KPd, DPd, or IPd
If daratumumab, isatuximab, carfilzomib, or pomalidomide are not available: VCd, Vd, or VMP
DKd=daratumumab + carfilzomib + dexamethasone; DPd=daratumumab + pomalidomide + dexamethasone; DRd=daratumumab + lenalidomide + dexamethasone; DVd=daratumumab + bortezomib + dexamethasone; Elo‒Rd=elotuzumab + lenalidomide + dexamethasone; IPd=ixazomib + pomalidomide + dexamethasone; IRd=ixazomib + lenalidomide + dexamethasone; Isa‒Kd=isatuximab + carfilzomib + dexamethasone; Kd=carfilzomib + dexamethasone; KPd= carfilzomib + pomalidomide + dexamethasone; KRd=carfilzomib + lenalidomide + dexamethasone; PVd=pomalidomide + bortezomib + dexamethasone; Rd=lenalidomide + dexamethasone; SVd=selinexor + bortezomib + dexamethasone; VCd=bortezomib + cyclophosphamide + dexamethasone; Vd=bortezomib + dexamethasone; VMP=bortezomib + melphalan + prednisone; VTd=bortezomib + thalidomide + dexamethasone. Moreau P, et al. Lancet Oncol. 2021;22(3):e105-e118.
Reprinted from The Lancet Oncology, Volume 22, Moreau P, et al., “Treatment of relapsed and refractory multiple myeloma: recommendations from the International Myeloma Working Group,” pages e105–e108, ©2021, with permission from Elsevier.Any first relapse options that have not been tried; Isa–Pd, DKd, DPd, or Isa–Kd (based on phase 3 trial data*); or Elo–Pd or KPd (based on data from phase 2 trials†)
When daratumumab, carfilzomib, or elotuzumab are unavailable: PCd or Pd

Approved: selinexor, VdT-PACE, BCMAdirected CAR T-cell therapy (4 lines), or teclistamab (4 lines)1-7
Other options (investigational agents): venetoclax in t(11;14) or BCL2 high expression1-7
Reprinted from The Lancet Oncology, Volume 22, Moreau P, et al., “Treatment of relapsed and refractory multiple myeloma: recommendations from the International Myeloma Working Group.,” pages e105–e108, ©2021, with permission from Elsevier.
*Grade of recommendation: 1A. †Grade of recommendation: 1B. BCL2=B cell lymphoma 2; BCMA=B-cell maturation antigen; CAR=chimeric antigen receptor; DKd=daratumumab + carfilzomib + dexamethasone; DPd=daratumumab + pomalidomide + dexamethasone; Elo‒Pd=elotuzumab + pomalidomide + dexamethasone; Isa‒Kd=isatuximab + carfilzomib + dexamethasone; Isa‒Pd=isatuximab + pomalidomide + dexamethasone; KPd=carfilzomib + pomalidomide + dexamethasone; PCd=pomalidomide + cyclophosphamide + dexamethasone; Pd=pomalidomide + dexamethasone; VdT -PACE=bortezomib + dexam ethasone + thalidomide + cisplatin + doxorubicin + cyclophosphamide + etoposide.
1. Moreau P, et al. Lancet Oncol. 2021;22(3):e105-e118. 2. Tecvayli. Prescribing information. Janssen Biotech, Inc; 2022. 3. Carvykti. Prescribing information. Janssen Biotech, Inc; 2022. 4. Abecma. Prescribing information. Celgene Corporation, a Bristol-Myers Squibb Company; 2021. 5. Department of Health and Human Services. Federal Register. 87(57):16742-16743. 6. GSK. https://www.gsk.com/en-gb/media/press-releases/gsk-provides-update-on-blenrep-us-marketing-authorisation/. Accessed December 10, 2022. 7. Olivier T and Prasad V. Transl Oncol. 2022;18:101374.
There is no clear consensus for treatment following second or later relapse
• It is not a simple algorithm of treatment #1 then 2 then 3…
• Leverage the benefit of multiple mechanisms of action in combination therapy
Categories:

• 1-3 prior lines
• Later Relapse
• Refractory to PI, IMiD and MoAb = Triple Class Refractory
Principles
1. Depth of Response matters…likely incorporate MRD soon
2. High risk vs standard risk…more aggressive Rx in high risk
3. Balance efficacy and toxicity…initially and constantly assess
4. Overcome drug resistance…change mechanism of action when possible
Key eligibility criteria
• RRMM
• ≥1 prior line of therapy



• Prior lenalidomide exposure, but not refractory
• Creatinine clearance
≥30 mL/min
DRd (n = 286)

Daratumumab 16 mg/kg IV
• Qw in Cycles 1 to 2, q2w in Cycles 3 to 6, then q4w until PD
R 25 mg PO
• Days 1 to 21 of each cycle until PD
d 40 mg PO
• 40 mg weekly until PD
Rd (n = 283)
R 25 mg PO
• Days 1 to 21 of each cycle until PD
d 40 mg PO
• 40 mg weekly until PD
Stratification factors
• No. of prior lines of therapy
• ISS stage at study entry
• Prior lenalidomide
Cycles: 28 days
Primary endpoint
• PFS
Secondary endpoints


• TTP
• OS
• ORR, VGPR, CR
• MRD
• Time to response
• Duration of response
Statistical analyses
• Primary analysis: ~177 PFS events
Pre-medication for the DRd treatment group consisted of dexamethasone 20 mg,a acetaminophen, and an antihistamine
ISS, international staging system; DRd, daratumumab/lenalidomide/dexamethasone; IV, intravenous; qw, weekly; q2w, every 2 weeks; q4w, every 4 weeks; PD, progressive disease; R, lenalidomide; PO, oral; d, dexamethasone; Rd, lenalidomide/dexamethasone; PFS, progression-free survival; TTP, time to progression; OS, overall survival; ORR, overall response rate; VGPR, very good partial response; CR, complete response; MRD, minimal residual disease. aOn daratumumab dosing days, dexamethasone 20 mg was administered as pre-medication on Day 1 and Day 2.
Multicenter, randomized (1:1), open-label, active-controlled, phase 3 study
not reached
17.5 months
Median follow-up: 32.9 months (range, 0 - 40.0 months)
56% reduction in risk of progression/death for DRd versus Rd
HR, hazard ratio; CI, confidence interval. aExploratory analyses based on clinical cut-off date of October 23, 2017; bKaplan- Meier estimate.
Median
PFS, mos
PFS 100 0 0 1 2 3 4 5 6 7 8 9 10 11 12 13 14 15 16 Mos 154 153 129 105 106 80 89 63 81 51 52 33 317 14 5 1 0
Isatuximab-Pd 11.53 Pd 6.47


• Phase III ICARIA-MM: Isatuximab + Pom/Dex vs Pom/Dex in R/R MM
HR: 0.596 (95% CI: 0.4360.814); P = .001 No. at risk Isa-Pd Pd
PFS HR (95% CI)
Len refractory: 0.59 (0.43-0.82)

Len refractory in last line: 0.50 (0.340.76)
• Phase III IKEMA IsaKD vs KD
• FDA approved isatuximab in combination with pomalidomide or carfilzomib
Antigen Function

BCMA Long-term survival of plasma cells2
FcRH5 Regulates BCR signaling and binds to IgG2
GPRC5D Possible role in cell proliferation2
SLAMF7 Possible role in cell survival 2,3
CD38
Regulation of calcium homeostasis, signaling, and adhesion2
CD138
Adhesion, proliferation, angiogenesis, suppression of apoptosis and metastasis2
CD47
Immune checkpoint that triggers inhibition of macrophage phagocytic activity1
BCL2=B-cell lymphoma-2; BCMA=B-cell maturation antigen; BCR=B-cell receptor; CD=cluster of differentiation; CUL4A=Cullin 4A; eEF1A2=eukaryotic translation elongation factor 1 alpha 2; Fc=fragment crystallizable; FcRH5=FC receptor homologue 5; GPRC5D=G protein-coupled receptor class C group 5 member D; HDAC=histone deacetylase; IgG=immunoglobulin G; IKZF=Ikaros zinc finger; IRF4=interferon regulatory factor 4; MM=multiple myeloma; SLAMF7=signaling lymphocyte activation molecule family member 7; XPO1=exportin 1.
Antigens that are highly expressed on the surface of malignant cells are promising targets in MM1-3



Antibody Drug Conjugate T-Cell Bispecific Antibody T-Cell Trispecific Antibody


• Receptor for BAFF and APRIL
• Expressed on mature B cell subsets, PC’s, and plasmacytoid DC’s
• Maintains plasma cell homeostasis
• BCMA-/- mice have normal B cell #s, impaired PC survival
Hengeveld et al Bl Cancer J 2015 ; Maus, June, Clin Can Res 2013

Four mechanisms of action:
• Belantamab mafodotin (GSK2857916) : Humanized, afucosylated, IgG1 BCMA-targeted ADC that neutralizes soluble BCMA
• Preclinical studies demonstrate selective, potent activity Belantamab Mafodotin
–MMAF (non–cell-permeable, highly potent auristatin) Cytotoxic agent
1. ADC
2. ADCC
3. Immunogenic cell death
4. BCMA receptor signaling inhibition
–Enhanced ADCC Afucosylation
Linker
–Stable in circulation
• Belantamab mafodotin
– ADC: Anti-BCMA mAb conjugated to auristatin F through a non-cleavable linker
R/R MM ≥ 3 prior lines of therapy
N = 293
R 1:1
Belantamab mafodotin 2.5 mg/kg IV (frozen)
Belantamab mafodotin 3.4 mg/kg IV (frozen)
Belantamab mafodotin 3.4 mg/kg IV (lyophilized)
Primary Endpoint: •ORR: % of patients with ≥ PR by IMWG 2016 criteria
Belantamab mafodotin administered once every 3 weeks until disease progression or unacceptable toxicity
Belantamab mafodotin-blmf (2.5 mg/kg): FDA accelerated approval on August 5, 2020 for R/R MM after
≥ 4 prior therapies, including an anti-CD38 monoclonal antibody, a PI, and an immunomodulatory agent
Lonial S, et al. Lancet Oncol. 2020;21:207-221; https://www.fda.gov/drugs/drug-approvals-and-databases/fda-granted-accelerated-approvalbelantamab-mafodotin-blmf-multiple-myeloma FDA.gov
Overall Response Rate1
15% (n=15)



60% of responding patients (n=18/30) had a very good partial response or better1
12% (n=12) PR

BsAbs engage BCMA on MM cells and CD3 on T cells, bringing T cells into close proximity to MM cells1,2
Recruitment of cytotoxic T cells to MM cells leads to formation of a cytolytic synapse3
Cytolytic enzymes are released with the ability to induce tumor cell lysis1,3
BsAbs act independently of the MHC, generating a robust T-cell response, activating cytotoxic CD8+ T cells as well as regulatory and helper CD4+ T cells, without the need for co-stimulatory molecules1,3
maturation antigen; CD=cluster of differentiation; mAb=monoclonal antibody; MHC=major histocompatibility complex; MM =multiple myeloma.

Chimeric antigen receptor T cells (CAR-T)
Pros Unprecedented ORR including MRD neg in heavily pre-treated patients
Bispecific antibodies
Antibody-drug conjugates
Con s Manufacturing time makes impractical for patients with aggressive/rapidly progressing disease
Requires complex infrastructure – stem cell lab, RN/ ICU/ER training – thus restricted to accredited centers
CRS ? role in frail elderly
Impact of bridging chemo on remission duration
Low WBC and plts post CAR-T
Cost given relapses even in MRD neg patients; mgmt. challenging especially if soon after flu/cy given impact on T cells
Off
Deep responses
Limited severe CRS - ? Safety in frail elderly
Can be given in community settings after 1st cycle the shelf
? Need for admissions with initial doses until CRS risk low
Dosing/schedule to be determined
Need for continuous treatment until progression
Toxicities require further study –infections, neurotoxicty
Encouraging response rates
1 hour infusion every 3 weeks
No CRS, can be given in community settings
Ocular toxicity – requires close collaboration with opthamology & impact on pt quality of life
Thrombocytopenia
Need for continuous treatment until progression
Modest ORR and PFS in triple class/penta refractory
Lancman, et al. ASH 2020
Nikhil C. Munshi, M.D., Larry D. Anderson, Jr., M.D., Ph.D., Nina Shah, M.D., Deepu Madduri, M.D., Jesús Berdeja, M.D., Sagar Lonial, M.D., Noopur Raje, M.D., Yi Lin, M.D., Ph.D., David Siegel, M.D., Ph.D., Albert Oriol, M.D., Philippe Moreau, M.D., Ibrahim Yakoub-Agha, M.D., Ph.D., Michel Delforge, M.D., Michele Cavo, M.D., Hermann Einsele, M.D., Hartmut Goldschmidt, M.D., Katja Weisel, M.D., Alessandro Rambaldi, M.D., Donna Reece, M.D., Fabio Petrocca, M.D., Monica Massaro, M.P.H., Jamie N. Connarn, Ph.D., Shari Kaiser, Ph.D.,

Payal Patel, Ph.D., Liping Huang, Ph.D., Timothy B. Campbell, M.D., Ph.D., Kristen Hege, M.D., and Jesús San-Miguel, M.D., Ph.D.
N Engl J Med 2021
Volume 384(8):705-716
February 25, 2021




• Not all relapses are the same.
• Combination therapies provide better outcomes.

• Available drugs and combinations are increasing.
• The optimal therapy is the one based on your needs.
• We need to get it right at first relapse.















Patient and Family Webinars: Virtual PFW – May 17, 2023 – keep an eye on our website for registration for this virtual program. It will air LIVE at 5:30PM PST

Los Angeles – August 18 & 19, 2023 – details to be announced, this event will have an international myeloma expert presenting!

Thank you for attending today's program!
April 22, 2023, International Myeloma Foundation’s Regional Community Workshop –Seattle.
